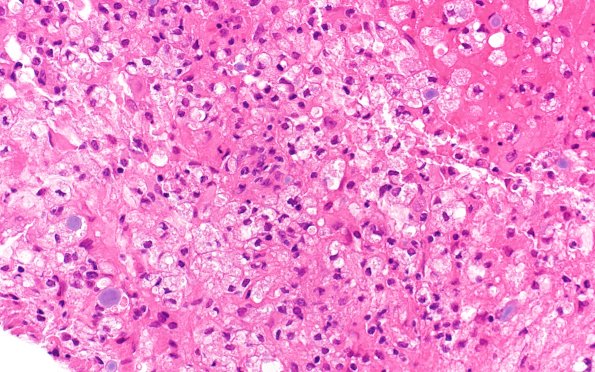
17B3 Demyelination, inflammatory (Case 17) H&E 40X 2

Table of Contents
Washington University Experience | MYELIN (IMMUNE-MEDIATED) | Inflammatory Demyelination | 17B3 Demyelination, inflammatory (Case 17) H&E 40X 2
17B3,4 Higher magnification appearance of the composition of the cellularity. Scattered corpora amylacea are admixed with foamy macrophages. (H&E)